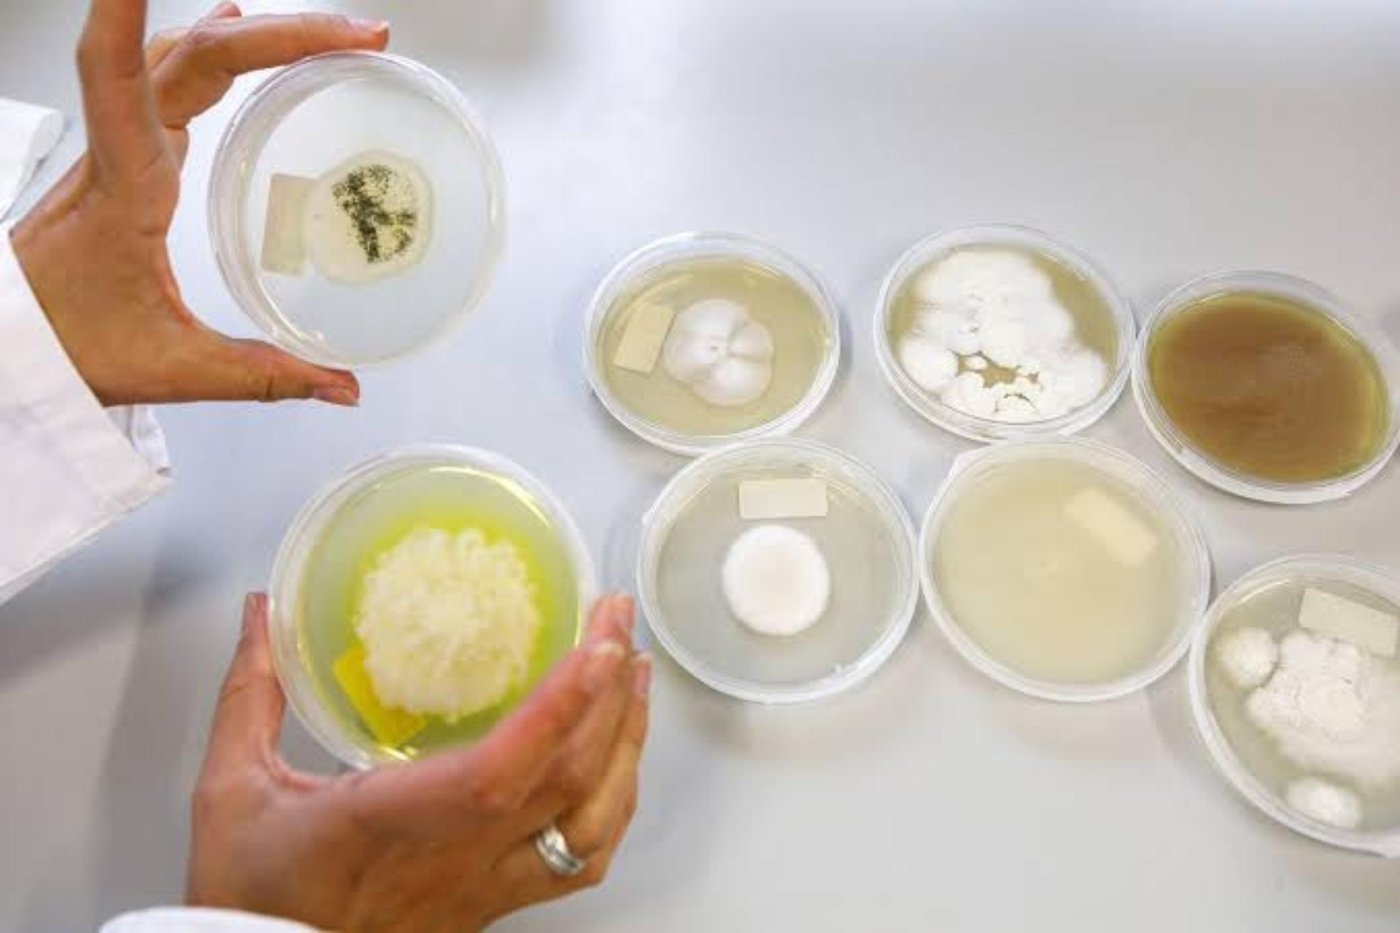
Vlaamse startup Zymofix groeit uit in Europa, mede door de steun van Enterprise Europe Network Vlaanderen

De innovatieve startup Zymofix is uitgegroeid tot een Europese scale-up. De realisatie van hun internationale ambities werd mee mogelijk gemaakt door de 3 miljoen euro aan subsidies en de steun van Enterprise Europe Network Vlaanderen.
Zij maakten het bedrijf wegwijs in het internationaal ondernemen. “Elk succesverhaal begint met een eerste stap. En die stap hoef je niet alleen te zetten”, weet Patrick De Molder, adviseur bij Enterprise Europe Network Vlaanderen (EEN Vlaanderen), een netwerk dat bedrijven met internationale ambities onder zijn vleugels neemt.
“We hadden al een mooi parcours afgelegd en voelden dat er ook buiten Vlaanderen mogelijkheden waren voor onze technologie”, zegt Emile Redant, CEO van Zymofix. Het biotechbedrijf focust momenteel op duurzame landbouw, maar heeft de ambitie om hun technologie ook in andere sectoren in te zetten. “Onze micro-organismen stimuleren de groei van planten of beschermen ze tegen bepaalde stress. Maar op termijn zien we ook mogelijkheden met micro-organismen in bijvoorbeeld, bioremediatie, afvalverwerking en andere industrieën. We streven ernaar om afval om te zetten naar waardevolle grondstoffen die ecosystemen kunnen helpen.”
Concrete begeleiding
Zymofix had reeds een beroep gedaan op VLAIO, maar ook voor hun internationale ambities bleek het Vlaams overheidsagentschap een waardevolle partner. "Ze wisten dat er internationale mogelijkheden waren, maar het ontbrak hen aan overzicht”, vertelt Patrick De Molder, adviseur bij VLAIO en waar hij internationaal actief is binnen Enterprise Europe Network Vlaanderen. EEN Vlaanderen is overigens een consortium tussen VLAIO en FIT. “Hoe vind je als jonge startup je weg in internationaal ondernemen? Vaak is het complex en overweldigend. Dat is waar Enterprise Europe Network Vlaanderen het verschil kan maken." Wat volgde was een intensief traject met adviezen en concrete begeleiding.

Europees innovatieprogramma
EEN Vlaanderen wees Zymofix op de European Innovation Council, een prestigieus en veeleisend Europees innovatieprogramma. Individuele bedrijven kunnen forse subsidies ontvangen, maar de lat ligt hoog. Je moet een gedegen dossier indienen, je pitch moet overtuigen, en je wordt beoordeeld door een jury van Europese experts. "Een ondernemer kan natuurlijk pitchen", zegt Patrick. Maar pitchen voor Europa is een ander verhaal. EEN Vlaanderen bood de nodige begeleiding aan: geen oppervlakkige tips, maar grondige oefensessies waarbij de pitch werd voorbereid."Het resultaat was dat Zymofix de jury met glans kon overtuigen en een subsidie ontving van 2,5 miljoen euro via de EIC Accelerator. Een bedrag dat hen ademruimte gaf, groei mogelijk maakte en internationale uitbreiding binnen handbereik bracht.
De uitbouw van een Europees netwerk
Heel snel ontvouwde er zich nog een tweede kans via Horizon Europe. Zij bieden zeer omvangrijke programma's aan, maar je moet wel deel uitmaken van een Europees consortium. Een grote uitdaging voor een Vlaamse startup. Waar vind je betrouwbare partners in andere landen? Hoe bouw je een geloofwaardig voorstel op? En hoe zorg je dat alle partijen dezelfde taal spreken, zowel letterlijk als figuurlijk? "Met Enterprise Europe hebben we meegezocht naar mogelijke partners”, legt Patrick uit. "We hebben een database, we organiseren matchmaking-evenementen, en binnen Horizon Europe bestaan er ook speciale gelegenheden om elkaar te ontmoeten."
Via Enterprise Europe Network kwam Zymofix terecht bij een Spaanse organisatie die bereid was om als coördinator op te treden. Samen met andere Europese spelers werd een dossier opgemaakt binnen het programma Regional Innovation Valleys. Met succes, want er volgde een subsidie van 420.000 euro. Niet alleen voor Zymofix was dit goed nieuws, maar ook voor EEN Vlaanderen. Zij kregen de kans om het programma van de Regional Innovation Valleys beter te leren kennen en dit te promoten bij andere Vlaamse bedrijven. Het illustreert mooi de wisselwerking die Enterprise Europe Network nastreeft. Ze groeien als het ware mee met de ondernemers die ze begeleiden.
Aanpak op maat van het bedrijf
Of je nu een startup bent met internationale dromen of een gevestigd bedrijf dat de Europese markt op wil: er is geen kant-en-klare route. Die boodschap wil Enterprise Europe Network uitdragen naar alle ondernemers. “Elk bedrijf is anders, elke sector heeft zijn eigenheid, elke ondernemer staat voor unieke uitdagingen”, benadrukt Patrick. “Als je internationaal wil ondernemen of innoveren, kom dan zeker eens praten. Wij bekijken wat we kunnen bieden op maat van het bedrijf."
Soms is er alleen een korte afstemming nodig om de juiste richting te wijzen. Soms is het intensief traject, zoals bij Zymofix, waarbij lang wordt samengewerkt aan dossiers, pitches en het uitbouwen van een internationaal netwerk. "We zien elke keer opnieuw wat onze meerwaarde is en wat de meerwaarde is van onze Vlaamse partners en buitenlandse EEN collega' in deze client journey om het bedrijf zo goed mogelijk verder te helpen. Dat is het mooie, maar ook het uitdagende aan onze job", weet Patrick.
De kracht van Enterprise Europe Network
Die meerwaarde zit voor een groot deel in het netwerk. Enterprise Europe Network telt 600 organisaties verspreid over 55 landen. Voor Zymofix hebben we de buitenlandse EEN collega’s op het gebied van bio-economie aangesproken. Voor andere vragen zoeken we telkens naar de experts in specifieke regio's en partners die dezelfde taal spreken als jouw bedrijf. EEN Vlaanderen kan dat netwerk inschakelen, verbindingen leggen en deuren openen die anders gesloten blijven.
Voor Zymofix was dat netwerk de sleutel tot succes. Zonder de Spaanse coördinator was er geen consortium geweest. Zonder de expertise van EEN Vlaanderen was de pitch misschien niet overtuigend genoeg geweest. En zonder de databases, matchmaking evenement en netwerken kunnen bedrijven mogelijk jaren zoeken naar de juiste partners.
Maar het netwerk is meer dan een adressenbestand. Het is een gemeenschap van mensen die begrijpen wat internationaal ondernemen betekent. Die weten hoe Europese programma's in elkaar steken. Die de codes kennen, de verwachtingen begrijpen en de valkuilen kunnen vermijden.
Dienstverlening met impact
Voor EEN Vlaanderen is het succes van Zymofix ook strategisch belangrijk. Europa financiert het werk van Enterprise Europe Network en steeds vaker wordt er naar impact van de dienstverlening gevraagd. Heeft onze dienstverlening voor extra omzet, extra tewerkstelling en dergelijke gezorgd”. Wat Zymofix betreft, is het een duidelijk verhaal. Het bedrijf is gegroeid, heeft kapitaal opgehaald en subsidies binnengebracht. Daarnaast staat het op het punt om internationaal verder uit te breiden en te investeren in een nieuwe fabriek in Vlaanderen.
Met dit soort verhalen wil EEN Vlaanderen andere ondernemers inspireren. “We willen laten zien dat internationale groei zelfs voor jonge bedrijven mogelijk is. Daarnaast willen we duidelijk maken dat je die groei niet alleen hoeft te realiseren.
Geen privilege voor grote spelers
De case van Zymofix toont aan dat internationaal ondernemen geen privilege is voor grote spelers. Ook startups en scale-ups kunnen Europese subsidies binnenhalen, een internationaal netwerk opbouwen en groeien over de grenzen heen. Al vraagt het wel de juiste begeleiding, kennis van systemen en niet onbelangrijk de toegang tot de juiste mensen. “Wij denken mee en zijn een gids in een complex landschap”, zegt Patrick. “We geven geen garantie op succes, maar staan wel klaar met een netwerk dat de wereld omspant en openen deuren die anders gesloten zouden blijven.
Voor ondernemers met internationale ambities is de boodschap helder: de weg naar Europa is begaanbaar. De subsidies zijn er. De kansen liggen voor het oprapen. Bij Enterprise Europe Network Vlaanderen weten ze: elk succesverhaal begint met een eerste stap. En die stap hoef je niet alleen te zetten.